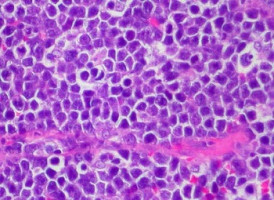
Scientists finally discover which prostate cancers are life-threatening

Cancer Research UK scientists have discovered that the presence of a specific protein can distinguish between prostate cancers that are aggressive and need further treatment from those that may never seriously harm the patient.
The study, published in Oncogene, found much higher levels of the protein, NAALADL2, in prostate cancer tissue compared with healthy tissue.
The difference was especially marked in aggressive prostate cancer tumours and cancer cells that had already spread around the body.
The team confirmed in two independent patient groups that the protein could be used to diagnose prostate cancer. But, even more importantly, it found that high levels of the protein could potentially pinpoint those patients with aggressive disease who would need surgery, chemotherapy and radiotherapy. Patients with lower levels of the protein were more likely to need monitoring rather than treatment.
After years of trying to unlock the secret of which prostate cancers are life-threatening – sometimes referred to as ‘tigers’, and which are essentially harmless ‘pussycats’, this new discovery could revolutionise how doctors treat the disease.
The protein NAALADL2 causes prostate cancer cells to behave more aggressively, making them more likely to move and invade healthy tissue surrounding the tumour.
Lead author, Dr Hayley Whitaker, Cancer Research UK scientist at the University of Cambridge, said: “This is early research, but if clinical trials confirm our results then it could help clinicians to tell which patients have a more aggressive tumour and need proportionally aggressive treatment, while sparing patients with low grade tumours a unnecessary radiotherapy or surgery.
“This is an important step along the path to developing a much-sought after test that could distinguish between different types of prostate cancer.”
Around 41,000 men per year are diagnosed with prostate cancer in the UK and around 10,700 men die from the disease annually.
There are a number of diagnostic tests available for the disease. The best known is the Prostate Specific Antigen Test (PSA), which detects a wide variety of prostate cancers. But it cannot distinguish between the life-threatening and the relatively harmless forms of the disease, so is not reliable enough to be used in a national screening programme.
Professor Malcolm Mason, Cancer Research UK’s prostate cancer expert based at the University of Cardiff, said: “As a prostate cancer clinician, I have been waiting for years for a test that can define the aggressive disease. I hope that this research brings forward the day when I can say to patients: ‘We know that your cancer doesn’t need treatment’ – a crucial development that could spare thousands of patients from enduring arduous treatment with unpleasant side effects.
“This extremely interesting study provides an important development for prostate cancer screening, and potentially even reveals a new target for the development of new prostate cancer drugs in the future.
Source: CRUK